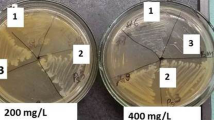

Abstract
Twelve bacterial species were evaluated to know the degradation pattern of thiamethoxam in liquid medium. All the bacterial species could actively degrade phorate in a mineral salt medium containing phorate (50 μg ml–1) as sole carbon source. As these species have ability to degrade, we used these for the degradation of thiamethoxam—a neonicoitinoids. Screening of 12 active phorate-metabolizing bacterial species resulted in selection of Bacillus aeromonas strain IMBL 4.1 and Pseudomonas putida strain IMBL 5.2 causing 45.28 and 38.23 % thiamethoxam (50 μg ml−1) reduction, respectively, in 15 days as potential thiamethoxam degrading species. These two bacterial species grew optimally at 37 °C under shake culture conditions in MSMT medium raised with initial pH of 6.0–6.5 and use of these optimum cultural conditions resulted in improved thiamethoxam degradation by these bacterial species. These species caused maximum thiamethoxam degradation only in the presence of thiamethoxam as sole source of carbon and energy and the same was reduced in the presence of easily metabolize able carbon (C0 and C1) and nitrogen ((N0, N1 and N2) sources. This could be attributed to involvement of repressible metabolic pathways, reactions of which are inhibited by the presence of easily available nutrients for growth. Besides above, qualitative analysis of thiamethoxam residues by gas liquid chromatography revealed complete metabolization of thiamethoxam without detectable accumulation of any known thiamethoxam metabolites.
Similar content being viewed by others
Explore related subjects
Discover the latest articles, news and stories from top researchers in related subjects.Avoid common mistakes on your manuscript.
Introduction
Insect pests have become major constraints for higher productivity in agricultural crops (Agriculture, Today 2009). To protect various crops from damaging effects of these insects, the demand for different pesticides is increasing one way or the other (FAO 2001). Worldwide, about 3 × 109 kg of pesticides is applied annually with a purchase of nearly $40 billion each year, and this use of pesticides is increasing day by day. About 241 pesticides are registered for use in India against various pests and diseases (CIBRC 2012). This extensive use of pesticides has improved the agricultural productivity many folds. However, excessive and continued use of these toxic and relatively non-biodegradable chemicals leads to a substantial health hazard resulting from active uptake and accumulation of these compounds in the food chain and drinking water (Mohamed 2009).
Thiamethoxam, (EZ)-3-(2-chloro-1,3-thiazol-5-ylmethyl)-5-methyl-1,3,5-oxadiazinan-4-ylidene (nitro) amine, is now the second biggest neonicotinoid (US$627 million) in terms of sales in 2009. Till date, thiamethoxam holds registration for 115 crop uses in at least 64 countries (Jeschke et al. 2011). It is one of the most used neonicotinoid insecticides and is amongst the most profitable pesticides worldwide being widely used for foliar, soil and seed treatment (Pandey et al. 2009). It is a new nitromethylene-derived neonicotinoid with contact, stomach and systemic activity. It is active against sucking and chewing insects like aphids, whiteflies, plant hoppers, thrips and beetles that attacks various crops like rice, maize, cotton, vegetables and mango (Gupta et al. 2008). However, its characteristic properties, such as low soil sorption and high leaching capability, make it potential contaminants of surface and underground waters (Urzedo et al. 2009). Neonicotinoids are not readily degraded and are considered as biorefractory pesticide pollutants and only limited microbial species have been reported to transform neonicotinoid insecticides (Wang et al. 2011). The discovery of microorganisms capable of tolerating or growing in high concentrations of insecticides provides a potential avenue for treating hazardous wastes. Current efforts on bioremediation of different insecticides stress upon isolation and characterization of pesticide-degrading microorganisms from the soil (Shetti and Kaliwal 2012).
Microbial metabolization of thiamethoxam in liquid cultures and inoculated soils has been reported by only a few number of species such as Ensifer adhaerens TMX-23-nitrogen-fixing and plant-growth-promoting rhizobacterium (Zhou et al. 2013), a Pseudomonas sp. (Pandey et al. 2009), Bacillus amyloliquefaciens IN937a, Bacillus pumilus SE34 and Bacillus subtilis FZB24 (Myresiotis et al. 2012), nicotine-degrading bacteria Acinetobacter sp. TW and Sphingomonas sp. TY (Wang et al. 2011). The catabolic pathways involve transformation of parent compound to nitrosoguanidine (=N–NO), desnitro (=NH) and urea (=O) metabolites (Pandey et al. 2009). Since microbial degradation using selected bacterial species offers the most attractive and cost effective bioremediation approach, this study reports on two bacterial species from agricultural soils expressing high thiamethoxam-metabolizing potential and evaluation of their potential in thiamethoxam-fortified liquid media for future exploitation in contaminated soil and water environments.
Material and methods
Bacteriological media
Two different types of bacteriological media were used in this study. Luria Bertani (LB) was used as general purpose medium consisted of (g l−1) bacteriological tryptone 10.0, bacteriological yeast extract 5.0, sodium chloride 10.0 and distilled water to make1.0 l. Mineral salt medium (MSM) as given by Shaw and Burns (2004) was used as minimal medium for enrichment of thiamethoxam-degrading bacterial species and their subsequent studies. This medium was consisted of (g l-1) Na2HPO4·12H2O 3.0, KH2PO4 1.0, ammonium ferric citrate 0.01, bacteriological yeast extract 0.1, trace element solution 10 ml and distilled water to make 1.0 l. Trace element solution was consisted of (g l−1): MgSO4·7H2O 10.0, CaCl2·2H2O 2.0 and MnSO4·H2O 3.0. Initial pH of these media was adjusted between 7.0–7.2 and medium was autoclaved at 15 psi of steam for 20 min. When needed, the medium was supplemented with bacteriological agar (at 1.6 %) before autoclaving to make solidified LB—or MSM—agar medium. The sterilized MSM was supplemented with calculated amounts of thiamethoxam stock (10 mg ml−1 in acetone) just before use to provide thiamethoxam (at 20 or 50 μg ml−1) as sole source of carbon, nitrogen and energy.
Source of thiamethoxam-degrading bacterial species
Twelve different bacterial species that were earlier isolated from agricultural soils for phorate ((O,O-diethyl-S-[(ethylthio) methyl] phosphorodithioate) degradation by this lab (Jariyal et al. 2013) were used for the studied of thiamethoxam degradation. These species are given in Table 1.
Screening of bacterial species for thiamethoxam degradation in liquid cultures
For studies on relative thiamethoxam degradation potential of individual bacterial isolates, 15 ml of MSM broth in 50-ml conical flasks supplemented with thiamethoxam, MSMT (at 50 μg ml−1) was inoculated with 500 μl of overnight-grown bacterial culture in LB (108 CFU ml−1). The bacterial species were allowed to grow at 37 ± 1 °C on an orbital shaker (120 rpm) for 15 days. During this period, 1-ml aliquots of each culture broth drawn at specific intervals (3, 8 and 15 days) were analysed for thiamethoxam contents. Similarly, incubated MSMT broth but without any bacterial inoculation served as respective controls.
Analysis of thiamethoxam
The technical grade analytical standard of thiamethoxam (purity 99.7 %) was procured from Sigma-Aldrich, India. Thiamethoxam (Actara 25WG) formulation was used for broth application. This formulation was obtained from M/S Syngenta India Ltd., Mumbai, India. Analysis of acetone extract of the formulation showed only thiamethoxam with no additional peak due to any contaminant that could interfere with thiamethoxam analysis. Moreover, thiamethoxam concentration was found to be accurate with respect to its purity as claimed by the manufacturers. All other solvents and reagents used in this study were of analytical reagent grade. The quantitative estimation of thiamethoxam was carried out using GLC equipped with 63Ni ECD (Electron Capture Detector). A capillary column Rtx-5 (30 m × 0.53 mm i.d. × 0.25 μm film thickness of 5 % diphenyl and 95 % dimethyl polysiloxane) with splitless mode was used for estimation of thiamethoxam. The working conditions of GLC were injector temperature of 280 °C, column temperature of 220 °C and detector temperature of 300 °C. During analysis carrier gas (N2) flow was maintained at 30 ml min−1. Before use, the column was primed with several injections of standard solution of thiamethoxam till a consistent response was obtained. Under these operating conditions, the retention time of thiamethoxam was found to be 7.591 min. The thiamethoxam in the sample was identified and quantified by comparison of the retention time and peak heights of the sample chromatograms with that of standard run under identical operating conditions.
Quantification of thiamethoxam degradation in culture broths
One-milliliter aliquots of culture broths were drawn at specific intervals (0, 3, 8 and 15 days) and each aliquot was transferred into individual separatory funnels. Each sample was diluted with 500-ml brine solution (near saturated sodium chloride solution) and the funnel contents partitioned three times into dichloromethane using 100, 75 and 50 ml of dichloromethane, respectively. The combined organic layers were collected and passed through anhydrous sodium sulphate along with glass wool and collected in 500-ml beakers. The dichloromethane fractions were concentrated to near dryness using rotary vacuum evaporator at <35 °C. The final volume was reconstituted to about 15 ml using acetone. Thiamethoxam contents in sample aliquots were quantified with the help of gas liquid chromatography (GLC). The contents of thiamethoxam in the final acetone extract were estimated by GLC. The thiamethoxam contents were quantified by using following formula:
Half-life period of thiamethoxam
The half-life of thiamethoxam was determined by the procedure specified by Johnson et al. (1992). The degradation kinetics of the total thiamethoxam was determined by plotting the log of residue concentration against time, and the coefficients of determination were calculated to determine the equations of best fit curves.
Effect of various cultural parameters (medium pH, temperature and aeration) on growth of bacterial species
Ability of bacterial species to potentially metabolize different insecticides is directly related to their growth rate (Chishti and Arshad 2012). Therefore, the effect of different cultural parameters—initial medium pH (5.5, 6.0, 6.5, 7.0, 7.5, 8.0, 8.5 and 9.0), incubation temperature (32, 37 and 42 °C) and aeration (shaking at 120 rpm vs. stationary conditions) on growth of bacterial isolate (in terms of OD600)—was studied in 15 ml of MSM broth supplemented with glucose at 0.5 % level (MSMG) as sole source of carbon and energy. Each medium aliquot was inoculated with 300 μl of overnight grown culture of a bacterial isolate to provide an initial OD600 of 0.030 ± 0.005. Using 1-ml aliquots of culture broth drawn at 24-h regular intervals, the growth of the bacterial isolate was recorded in terms of OD600 in an ‘Eppendorf Biophotometer’ up to 7 days.
Effect of supplemented carbon and nitrogen sources on thiamethoxam degradation in liquid cultures
The effect of glucose and ammonium sulphate as added carbon and nitrogen sources on thiamethoxam degradation by selected bacterial species was studied in thiamethoxam-supplemented (at 50 μg ml−1) MSM broth and raised with optimum pH. Glucose was used at constant level of 0.1 % to provide 0.04 % carbon. However, ammonium sulphate as nitrogen source was studied at two different levels (0.1 and 0.2 %) to provide C:N ratio of 1:1.34 and 1:1.67. Fifteen milliliters of so prepared media were inoculated with the bacterial inoculum to provide initial OD600 of 0.030 ± 0.005 and growth allowed at optimum temperature in an orbital shaking incubator (120 rpm). After 15 days of growth, the whole medium was analysed for bacterial growth (OD600) and contents of thiamethoxam through GLC as described earlier.
Results
Enrichment and isolation of bacterial species
Through enrichment, 12 bacterial species were previously isolated from sugarcane field and identified through 16S rDNA nucleotide sequence homology with GenBank database by Jariyal et al. (2013) which has the ability to degrade phorate, so we used these bacterial species for the degradation of thiamethoxam—a neonicotinoids.
Screening of bacterial species for thiamethoxam degradation
Thiamethoxam degradation by 12 different bacterial species was given in Table 1. These species exhibited thiamethoxam reduction over a wide range of 20.88 to 45.28 % after 15 days. In the control (uninoculated) treatment, thiamethoxam degraded slowly, showing a maximum reduction of only 8.80 % after 15 days. With most of bacterial species, the insecticide degradation improved with increase in growth period from 3 to 15 days. However, in this respect, different bacterial species differed significantly in the rate by which insecticide degradation by day 3 (Bacillus aerophilus strain IMBL 4.1, 20.80 %; Pseudomonas monteilii strain IMBL 4.3, 10.27 %; B. aerophilus strain IMBL 3.2, 22.57 % and Pseudomonas putida strain IMBL 5.2, 7.77 %) was improved to a maximum by day 15 (B. aerophilus strain IMBL 4.1, 45.28 %; P. monteilii strain IMBL 4.3, 34.44 %; B. aerophilus strain IMBL 3.2, 32.37 % and P. putida strain IMBL 5.2, 38.23 %). This might be having a relation with the biochemical mechanism utilized by these different bacterial species in insecticide metabolization. Compared to above, all the bacterial species caused active metabolization of thiamethoxam within 15 days of growth. But the values being higher with B. aerophilus strain IMBL 4.1 (45.28 %) followed by P. putida strain IMBL 5.2 (38.23 %) followed by P. monteilii strain IMBL 4.3 (34.44 %).
Half-life period of thiamethoxam
Based upon the data in Table 1, the relative thiamethoxam degradation potential of the different bacterial species was interpreted in terms of half-life (t1/2) period of thiamethoxam in the presence of growth of specific bacterial species (Table 2). For all the samples studied, the exponential relations were found to apply corresponding to the first-order rate equation. The total thiamethoxam residues did not follow the first-order kinetics because the R 2 values were less than 0.99 (Jariyal et al. 2013), except P. putida IMBL 5.1 which followed the first-order kinetics, R 2 values was 0.99 (Table 2). The highest potential of the two spices B. aerophilus IMBL 4.1 and P. putida IMBL 5.2 strain in most actively metabolizing thiamethoxam was also supported by the lowest calculated half-life for the dissipation of total thiamethoxam (18.58 and 21.20 days with high correlation coefficient values of 0.96 and 0.99, respectively) by the same amongst all the species evaluated (Table 2). In this study, the control, thiamethoxam was degraded by 8.80 % during 15 days, equivalent to a half-life of 103.79 days.
All further studies were conducted with two bacterial species, i.e. P. putida strain IMBL 5.2 and B. aerophilus strain IMBL 4.1, which were established to express maximum thiamethoxam degradation potential amongst all the earlier available bacterial species.
Effect of various cultural parameters (medium pH, temperature and aeration) on growth of bacterial species
Ability of bacterial species to potentially metabolize specific insecticides as major nutrients is directly related to their growth rate (Chishti and Arshad 2012). In view of above, the effect of medium pH, incubation temperature and aeration (shaking vs. stationary conditions) on cell growth (OD600) of P. putida strain IMBL 5.2 and B. aerophilus strain IMBL 4.1 is given in Fig. 1. Results suggest that these two bacterial species could grow over a broad range of incubation temperature (32–42 °C), but the optimum growth was achieved at a temperature of 37 °C (Fig. 1a). At this optimum temperature, irrespective of bacterial species the maximum growth was observed after an incubation period of 3 days, which in case of B. aerophilus and P. putida was recorded as OD600 of 1.341 and 1.560, respectively. The use of incubation temperature below or above 37 °C and incubation period more or less than 3 days resulted in significant decrease in cell growth, irrespective of bacterial specie. All the two bacterial species achieved maximum growth within 2–4 days of incubation, though growth was significantly higher under shaking conditions than in stationary cultures (Fig. 1b). Thus, shaking conditions were relatively more promising for efficient growth of these bacterial species and could be attributed to sample availability of air (oxygen) which supported efficient cell growth. These bacterial species however differed with respect to their growth requirement for medium pH. Although, these two bacterial species could grow efficiently over a wider pH range, the preference for this pH range differed amongst the two species. Thus, whereas B. aerophilus had its maximum growth in a pH ranges of 5.0–7.0 with optima at pH of 6.0 (Fig. 1c). However, maximum growth of P. putida was observed at pH of 6.5. At an optimum pH of 6.5, the maximum growth of P. putida (OD600 = 2.068) was reached after an optimum incubation period of 3 and 4 days, respectively. However, under similar conditions, B. aerophilus achieved its maximum growth (OD600 = 2.010) at a medium pH of 6.0 after the incubation period of 3 days. Continuing the growth at optimum medium pH beyond above-mentioned optimum incubation conditions resulted in a slight decline in growth in all the bacterial species. Besides above, whereas growth of B. aerophilus at pH higher than its respective optimum pH range was drastically affected, P. putida could grow efficiently at medium pH higher than their respective optimum pH range. These results suggested that the two bacterial species could grow optimally at a pH range of 6.0–6.5, and P. putida are more or less alkalophillic bacterial species.
Effect of supplemented carbon and nitrogen sources on thiamethoxam degradation
Thiamethoxam degradation by B. aerophilus and and P. putida was studied in MSMT medium that had been supplemented with additional carbon (as glucose) and nitrogen (as ammonium sulphate) sources to possibly support higher degradation through improved bacterial growth. Whereas effect of glucose was studied at a single level (C0 and C1—0.0 and 0.1 % glucose, respectively), effect of ammonium sulphate as additional nitrogen source was evaluated at two different levels (N0, N1 and N2—0.0 %, 0.1 % and 0.2 %, respectively). The so-prepared MSMT media raised with optimum pH of 6.5 were inoculated with the bacterial inoculum of individual bacterial species and incubated as described in material and methods. After 15 days of incubation, results on its comparative growth and thiamethoxam degradation under different treatments are given in Table 3. Thiamethoxam degradation in uninoculated control treatments remained low (6.02–6.93 %). Under unsupplemented conditions (C0N0), the cell growth of B. aerophilus and P. putida remained low (OD600 = 0.484 to 0.510) but was associated with maximum reduction in thiamethoxam, i.e. 59.03 and 51.19 %, respectively. Availability of additional nitrogen (C0N1) as well as carbon source (C1N1, C1N2) in the amended MSMT resulted in improved growth of these bacterial species. However, this increase in growth due to additional presence of carbon and nitrogen sources (C0N1, C1N1 and C1N2) was associated with parallel decrease in thiamethoxam reduction, i.e. 56.37 to 49.26 and 45.52 to 40.81 %, respectively by these bacterial species. Thus, the decline in thiamethoxam degradation as compared to unammended MSMT was enhanced in the presence of additional nitrogen (C0N0 → C0N1) and further with the increase in level of nitrogen in the presence of additional carbon (C1N1 → C1N2). Though the study did not include an analysis for degradation products of thiamethoxam, GLC chromatograms of culture extracts always showed only one peak specific to thiamethoxam only with complete absence of peaks due to any possible degradation product of the same suggesting a complete metabolization of this insecticide to metabolites that are not detectable by GLC (Fig. 2).
Discussion
Agricultural soils that are being repeatedly exposed to different pesticides serve as a natural niche supporting the growth and activity of a variety of microorganisms including those having potential to degrade the respective xenobiotics. Several microbial species have been isolated by enrichment techniques and their potential to biodegrade specific insecticides in liquid culture media and in inoculated soils have been established (Singh et al. 2004; Kumar et al. 2012; Mandal et al. 2013; Jariyal et al. 2013). In this study, all the 12 bacterial species earlier isolated from agricultural soils by enrichment on thiamethoxam insecticide expressed low to high thiamethoxam-metabolizing abilities. Amongst these two species, i.e. B. aerophilus strain IMBL 4.1 and P. putida strain IMBL 5.2 had exhibited significantly higher thiamethoxam degradation potential. Studies suggested that these two bacterial species grow over a wide range of temperature and pH under shaking conditions. Optimum cultural parameters enhance the biodegradation of insecticide by bacterial species which is directly related to their growth rate (Chishti and Arshad 2012).
In case of the two selected bacterial species, i.e. B. aerophilus and P. putida in spite of improved growth, thiamethoxam degradation faced a decline by the presence of additional carbon and/or nitrogen. This was suggestive of that the thiamethoxam metabolization by these bacterial species is most likely repressed by the presence of easily available carbon and nitrogen sources and is stimulated by the absence of the same from the culture medium. Bacterial species involved in active degradation of different insecticide molecules are known to express their maximum potential only under nutrition-lacking conditions (Diez 2010; Jariyal et al. 2013). In this study, thiamethoxam degradation did not result in accumulation of any of its detectable metabolites. Compared to above, similar metabolization of imidacloprid—another neonicotide—by bacterial species belonging to Pseudomonas, Leifsonia, Stenotrophomonas, Enterobacter results in intermediate metabolites, some of which are more toxic than the parent compound (Anderson and Domsch 1980; Tomizawa and Casida 1999; Jariyal et al. 2013). Thus, the two bacterial species which were found to hold a maximum potential for thiamethoxam reduction through a potentially risk-free thiamethoxam degradation holds specific advantages for exploitation under practical conditions. However, further understanding on physiology, biochemistry and genetics of this bacterium will help in further enhancing its significance for purposeful exploitation in bioremediation of agricultural soils from toxic influence of thiamethoxam and its residues.
References
Agriculture, Today. (2009). Agriculture, most important area of India-US collaboration. The Hindu, Monday, July, 20, 2009 (www.hindu.com/2009/07/20/stories/htm).
Anderson, J. P. E., & Domsch, K. H. (1980). Influence of selected pesticides on the microbial degradation of 14C triallate and 14C diallate in soils. Archives of Environment Contamination and Toxicology, 9, 115–123.
Chishti, Z., & Arshad, M. (2012). Growth linked biodegradation of chlorpyrifos by Agrobacterium and Enterobacter spp. International Journal of Agriculture and Biology, 15, 19–26.
CIBRC. (2012). Insecticides/pesticides registered under section 9(3) of the Insecticides Act, 1968 for use in the country, Central Insecticides Board and Registration Committee, India (http://cibrc.nic.in/).
Diez, M. C. (2010). Biological aspects involved in the degradation of organic pollutants. Journal of Soil Science and Plant Nutrition, 10, 244–267.
FAO. (2001). Year book in pesticide information. January–March issue, pp 6–7, New Delhi.
Gupta, S., Gajbhiye, V. T., & Gupta, R. K. (2008). Soil dissipation and leaching behaviour of a neonicotenoid insecticide thiamethoxam. Bulletin of Environment Contamination and Toxicology, 80, 431–437.
Jariyal, M., Gupta, V. K., Mandal, K., Jindal, V., Banta, G., & Singh, B. (2013). Isolation and characterization of novel phorate-degrading bacterial species from agricultural soil. Environmental Science and Pollution Research. doi:10.1007/s11356-013-2155-2.
Jeschke, P., Nauen, R., Schindler, M., & Elbert, A. (2011). Overview of the status and global strategy for neonicotinoids. Journal of Agricultural and Food Chemistry, 59, 2897–2808.
Johnson, B., D., Dunlap, E., Tourigny, S., C. (1992). Documentation of procedures for filling out PESTCHEM data coding sheets. Environmental Monitoring Branch, DPR. http://em/docs/pubs/chem/procdrs.pdf.
Kumar, R., Singh, B., & Gupta, V. K. (2012). Biodegradation of fipronil by Paracoccus sp. in different types of soil. Bulletin of Environment Contamination and Toxicology, 88, 781–787.
Mandal, K., Singh, B., Jariyal, M., & Gupta, V. K. (2013). Microbial degradation of fipronil by Bacillus thuringiensis. Ecotoxicology and Environment Safety, 93, 87–92.
Mohamed, M. S. (2009). Degradation of methomyl by novel bacterial strain Stenotrophomonas maltophilia M1. Electronic Journal of Biotechnology, 12, 57–62.
Myresiotis, C., Vryzas, Z., & Papadopoulou-Mourkidou, E. (2012). Biodegradation of soil-applied pesticides by selected strains of plant growth-promoting rhizobacteria (PGPR) and their effects on bacterial growth. Biodegradation, 23, 297–310.
Pandey, G., Dorrian, S. J., Russell, R. J., & Oakeshott, J. G. (2009). Biotransformation of the neonicotinoid insecticides imidacloprid and thiamethoxam by Pseudomonas sp. 1G. Biochemical and Biophysical Research Communications, 380, 710–714.
Shaw, L. J., & Burns, R. G. (2004). Enhanced mineralization of [U-14C] 2,4-dichlorophenoxyacetic acid in soil from the rhizosphere of Trifolium pratense. Applied and Environmental Microbiology, 70, 4766–4774.
Shetti, A. A., & Kaliwal, B. B. (2012). Biodegradation of imidacloprid by soil isolate Brevundimonas sp. MJ15. International Journal of Current Research, 4, 100–106.
Singh, B. K., Walker, A., Morgan, J. A. W., & Wright, D. J. (2004). Biodegradation of chlorpyrifos by Enterobacter strain B-14 and its use in bioremediation of contaminated soils. Applied and Environmental Microbiology, 70, 4855–4863.
Tomizawa, M., & Casida, J. E. (1999). Minor structural changes in nicotinoid insecticides confer differential subtype selectivity for mammalian nicotinic acetylcholine receptors. British Journal of Pharmacology, 127, 115–122.
Urzedo, A. M., Nascentes, C. C., & Augusti, R. (2009). Degradation of the insecticides thiamethoxam and imidacloprid in aqueous solution as promoted by an innovative Fe°/Fe3O4 composite. Journal of the Brazilian Chemical Society, 20, 51–56.
Wang, M., Yang, G., Wang, X., Yao, Y., Min, H., & Lu, Z. (2011). Nicotine degradation by two novel bacterial isolates of Acinetobacter sp. TW and Sphingomonas sp. TY and their responses in the presence of neonicotinoid insecticides. World Journal of Microbiology and Biotechnology, 27, 1633–1640.
Zhou, G., Wang, Y., Zhai, S., Ge, F., Liu, Z., Dai, Y., Yuan, S., & Hou, J. (2013). Biodegradation of the neonicotinoid insecticide thiamethoxam by the nitrogen-fixing and plant-growth-promoting rhizobacterium Ensifer adhaerens strain TMX-23. Applied Microbiology and Biotechnology, 97, 4065–4074.
Acknowledgements
The authors are grateful to the Insect Molecular Biology Laboratory, Department of Entomology and Pesticide Residue Analysis Laboratory, Department of Entomology, Punjab Agricultural University, Ludhiana-141004, Punjab, India, for providing the necessary facilities.
Author information
Authors and Affiliations
Corresponding author
Rights and permissions
About this article
Cite this article
Rana, S., Jindal, V., Mandal, K. et al. Thiamethoxam degradation by Pseudomonas and Bacillus strains isolated from agricultural soils. Environ Monit Assess 187, 300 (2015). https://doi.org/10.1007/s10661-015-4532-4
Received:
Accepted:
Published:
DOI: https://doi.org/10.1007/s10661-015-4532-4